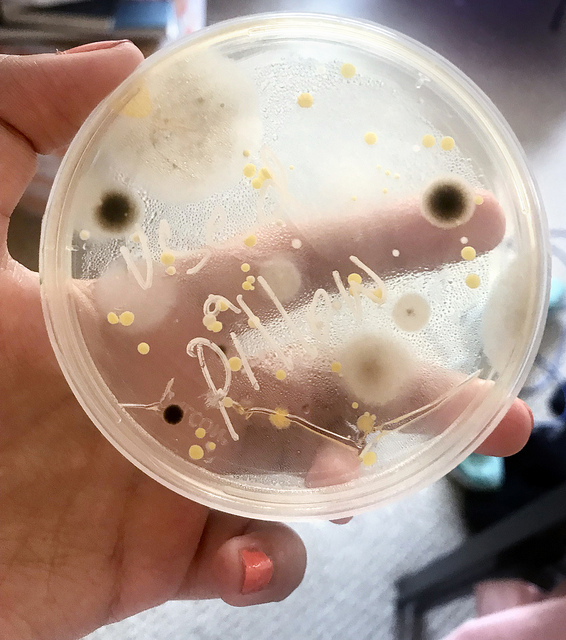

From fruit smoothie DNA to home-grown microbes, online summer course offers fun, hands-on science learning experiences
For most people, a fruit smoothie is a healthy, refreshing drink. For students who sign up for Plant Pathology 123 during Summer Term at the University of Wisconsin–Madison, there’s a lot more to the beverage: It’s also a fun, DIY science experiment.

Using their own kitchen blenders, students in this online summer course take strawberries, bananas and fruit juice and blend them into a “smoothie,” which breaks open the cell walls of the fruit. From there, they mix in a dash of dish soap, to rupture the plant cell membranes and release DNA. Next, students add a half-cup of rubbing alcohol, which causes the DNA to form white threads that can be gathered with a toothpick. And voila: fruit DNA.
“I saw DNA at home, in my kitchen, using just ethanol, soap and my fruit smoothie,” says Niharika Talwar, a UW–Madison computer science student. “How fantastic is that!”
Talwar was among the group of students who took Plant Pathology 123: Plants, Parasites, and People last summer. The eight-week, three-credit online course is open to any interested learners. It was designed with non-science majors in mind, to provide a fun and approachable option for fulfilling a science or lab requirement.
The course focuses on relevant examples — both cutting-edge and historic — to illustrate a range of scientific and biological concepts related to agricultural systems. Through lectures, labs and discussions, the class covers everything from the Irish potato famine to genetically engineered crops to biodiversity, as well as how these topics intersect with population growth, climate change and sustainability. The content is designed to be interesting and applicable, encouraging students to think critically about the role of science in everyday life.

“My goal is to have students come out of the class enriched in how they view food security, agriculture, and the impact of plant pathogens on society,” says course instructor Aurelie Rakotondrafara, an assistant professor in the plant pathology department. “I want them to become educated citizens who make informed decisions.”
Plant Path 123, as it’s known, has long been a popular course. During the academic year, there is often a waiting list to sign up for the traditional, in-person version of the course. That’s what inspired Rakotondrafara to develop the online version and offer it during the university’s Summer Term — to help increase options and flexibility for students. Rakotondrafara is one of several faculty members who take turns teaching the online course.
Across the university, many schools and colleges — including the College of Agricultural and Life Sciences (CALS) — are actively working to increase Summer Term offerings.
“Summer courses are a great way for students to get ahead in their studies,” says Karen Wassarman, CALS associate dean for academic affairs. “They can help students take a lighter load during the main academic year or help make sure they graduate on time, which can help students save money overall.”
Students cite other Summer Term benefits, as well.
“You can be vacationing anywhere in the world and you can take an online class and stay on track,” says Talwar. “I can pace myself, re-watch lecture videos, read notes provided, and make it work — while still enjoying my summer.”
Even though they don’t meet face to face, the online format manages to build a sense of a classroom community, particularly through the discussions and the sharing that the students do after watching lectures, reading course materials and completing labs. After the smoothie lab, for instance, students shared photos of their fruit DNA.
“Reading everyone’s opinions [on the online discussion board] is fun, and it helps me look at things differently, while in an in-person class, not everyone speaks up,” notes Talwar.
The most innovative part of the course is the at-home lab activities, which were a big challenge to develop, notes Rakotondrofara. To make it work, some lab materials are mailed to students, and they must also supply some of their own common household items.
Fortunately, the effort seems to have paid off. The at-home labs have proven popular with the students.
In another memorable lab, students collected microbial samples from two different surfaces of their own choosing and then let the samples incubate in a petri dish for five days to observe the microbial growth. Talwar chose to swab one of her pillows as well as her cell phone. In both cases, she found “a ton of fungi.” The results were a bit disconcerting — yet not surprising, considering the prevalence of microbes in our world.
That was just one of many good science lessons that Talwar learned during the course, which she recommends to other students.
“It is fun and so interesting,” says Talwar. “You study a topic and you think, ‘Oh my goodness. This was all around me all of this time, and I never noticed!’”
Registration for Summer Term starts on Apr. 1. All UW–Madison Summer Term courses are open to the general public. Some options, such as Plant Path 123, don’t have any prerequisite courses. For more information about Summer Term and a list of available courses, visit https://summer.wisc.edu/.